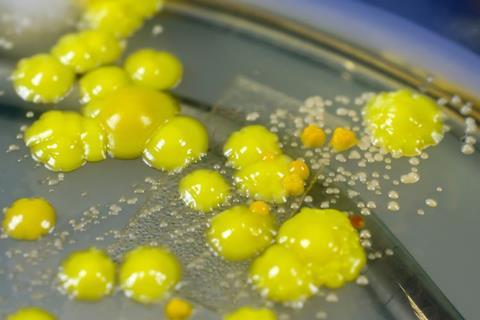
Image

Key factors behind the lengthy survival capabilities of the bacterium Micrococcus luteus (M. luteus) within a cleanroom have been reported in Tim Sandle’s recent paper.
A paper by Tim Sandle, Head of Microbiology, Risk Management and Sterility Assurance at Bio Products Laboratory Ltd has underlined the importance of proper cleanroom disinfection practices by elucidating on the robust survival mechanism of the bacterium Micrococcus luteus (M. luteus).
As “one of the most abundant organisms on the outer layer of human skin” M. luteus is a common contaminant recovered from cleanrooms, according to Sandle. It can be easily identified on a general nutrient medium agar plate, characterised by the production of yellow water-insoluble pigments.
Survival ability of M. luteus
Notably, excluding endospores, for the common vegetative bacteria, M. luteus can remain within a cleanroom for a long time if it is not directly eliminated using a disinfectant, Sandle reported in the paper published in The European Journal of Parenteral and Pharmaceutical Sciences (EJPPS).
The survival state that M. luteus enters into differs from actively growing states and is a form of dormancy. Microorganisms that survive for prolonged periods in cleanrooms are those that can tolerate, or undergo adaptive changes to, extreme desiccation and nutrient scarcity, Sandle wrote.
“Such organisms can undergo biochemical and physiological changes, essentially experiencing a reduced metabolic state which correlates with their ability to tolerate severe external stresses including starvation. Dormancy is comprised of different states, including persistent and viable but nonculturable (VBNC) states. Here cell division is suspended.”
Sandle stated it is important to note that the ability of M. luteus to withstand the stress of starvation for an extended time “is an important factor in the maintenance of its viability".
In addition to having robust survival capabilities, Sandle explained that under extreme conditions, such nutrient scarcity, M. luteus also demonstrates low sensitivity to elevated hydrostatic pressure where a minimal pressure between 100 and 350 MPa is required before cellular damage occurs.
A key feature of M. luteus is that not all the cells will survive and enter dormancy, Sandle explained. “There will be an initial rapid fall in cell numbers; after this, the small remaining population of M. luteus appears to be able to adapt to the harsh realities of the cleanroom environment.”
Application to the cleanroom
Discussing its ability to survive when under stress, Sandle stated that phenotypically, activation of a stress protein is thought to enhance its survival. Upon starvation, a static population of starved cells develops, and these enter a minimal metabolic state. To illustrate this point, he highlighted a study that showed that “a significant number” of M. luteus cells could be resuscitated after a prolonged period on a cleanroom bench.
In addition to reasons mentioned above, and because cleanrooms predominantly contain highly disinfectant-resistant Gram-positive strain bacteria, Sandle emphasised that “due consideration needs to be applied to the selection of the incubation regime (time and temperature) for the processing of environmental monitoring plates.”
Critically, he concluded that while environmental monitoring can never recover all organisms, organisms may be present but not necessarily recoverable using conventional environmental motoring methods. Or where organisms can be recovered, the time required for resuscitation might be longer. Therefore, the extensive survival ability of M. luteus “places an important emphasis on appropriate gowning and behaviours supported by a thorough cleaning and disinfection programme".
https://www.europeanpharmaceuticalreview.com/news/180833/identifying-origin-of-fungi-in-cleanrooms-fungi-contamination/


